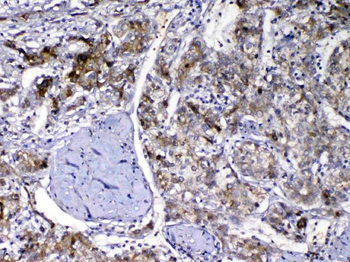
Vitamin D Binding protein/GC Antibody

You have no items in your shopping cart.
- CALB2 Antibody / Calbindin 2 / Calretinin [orb640003]
IHC-P, WB
Human
Mouse
Monoclonal
Unconjugated
100 μg, 20 μg - CALB2 Antibody / Calbindin 2 / Calretinin [orb2643946]
IHC-P, WB
Human
Mouse
Monoclonal
Unconjugated
100 μg - Calbindin 2 Antibody / CALB2 / Calretinin [orb2642792]
IHC-P, WB
Human
Mouse
Monoclonal
Unconjugated
100 μg - Vitamin D Binding protein/GC Antibody [orb402527]
ELISA, IHC, WB
Human, Mouse, Rat
Rabbit
Polyclonal
Unconjugated
100 μg - calbindin D28 Antibody [orb12289]
ELISA, IHC, WB
Human, Rat
Bovine, Canine, Porcine
Goat
Polyclonal
Unconjugated
100 μg - Human Vitamin D-binding protein (DBP) ELISA Kit [orb1807576]Featured

Human
0.16-10ng/mL
0.10 ng/mL
48 T, 96 T - Human Vitamin D Receptor (VDR) ELISA Kit [orb1807146]Featured

Human
0.63-40ng/mL
0.251 ng/mL
96 T, 48 T - Rat Vitamin D Binding Protein (DBP) ELISA Kit [orb1947236]Featured

Rat
15.63-1000ng/mL
9.38 ng/mL
96 T, 48 T - CALB1 Rabbit Polyclonal Antibody [orb5912]Featured

ICC, IF, IHC-Fr, IHC-P, WB
Human, Mouse, Rat
Bovine, Canine, Equine, Porcine, Rabbit
Rabbit
Polyclonal
Unconjugated
50 μl, 100 μl, 200 μl